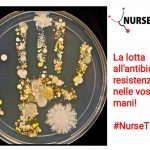
5 Maggio, giornata mondiale sull’igiene delle mani 2

L’ex tecnico del Manchester United è stato operato per un’emorragia subaracnoidea. Ora è in terapia intensiva.
È ricoverato da ieri sera al Salford Royal Hospital di Manchester, dove ha subito un delicato intervento chirurgico per un’emorragia subaracnoidea, Sir Alex Ferguson, leggenda del Manchester United e del calcio inglese. Dal quartier generale dell’Old Trafford il club ha reso noto, attraverso un comunicato stampa, che l’intervento ha avuto successo, ma che è ora necessario un periodo di osservazione in terapia intensiva allo scopo di ottimizzare il recupero.
La famiglia del 76enne ex calciatore e allenatore di origini scozzesi ha chiesto il massimo rispetto della privacy in un match così decisivo per lui, vincitore di numerosi campionati inglesi e competizioni europee, soprattutto con la squadra dello United, da lui guidata per ben 26 anni, fino al 2013. Sin dalla diffusione della notizia, nella tarda serata di sabato, continuano a fioccare gli attestati di stima e sostegno, oltre agli auguri di pronta guarigione da tutto il mondo del calcio.
Luigi D’Onofrio

Lascia un commento